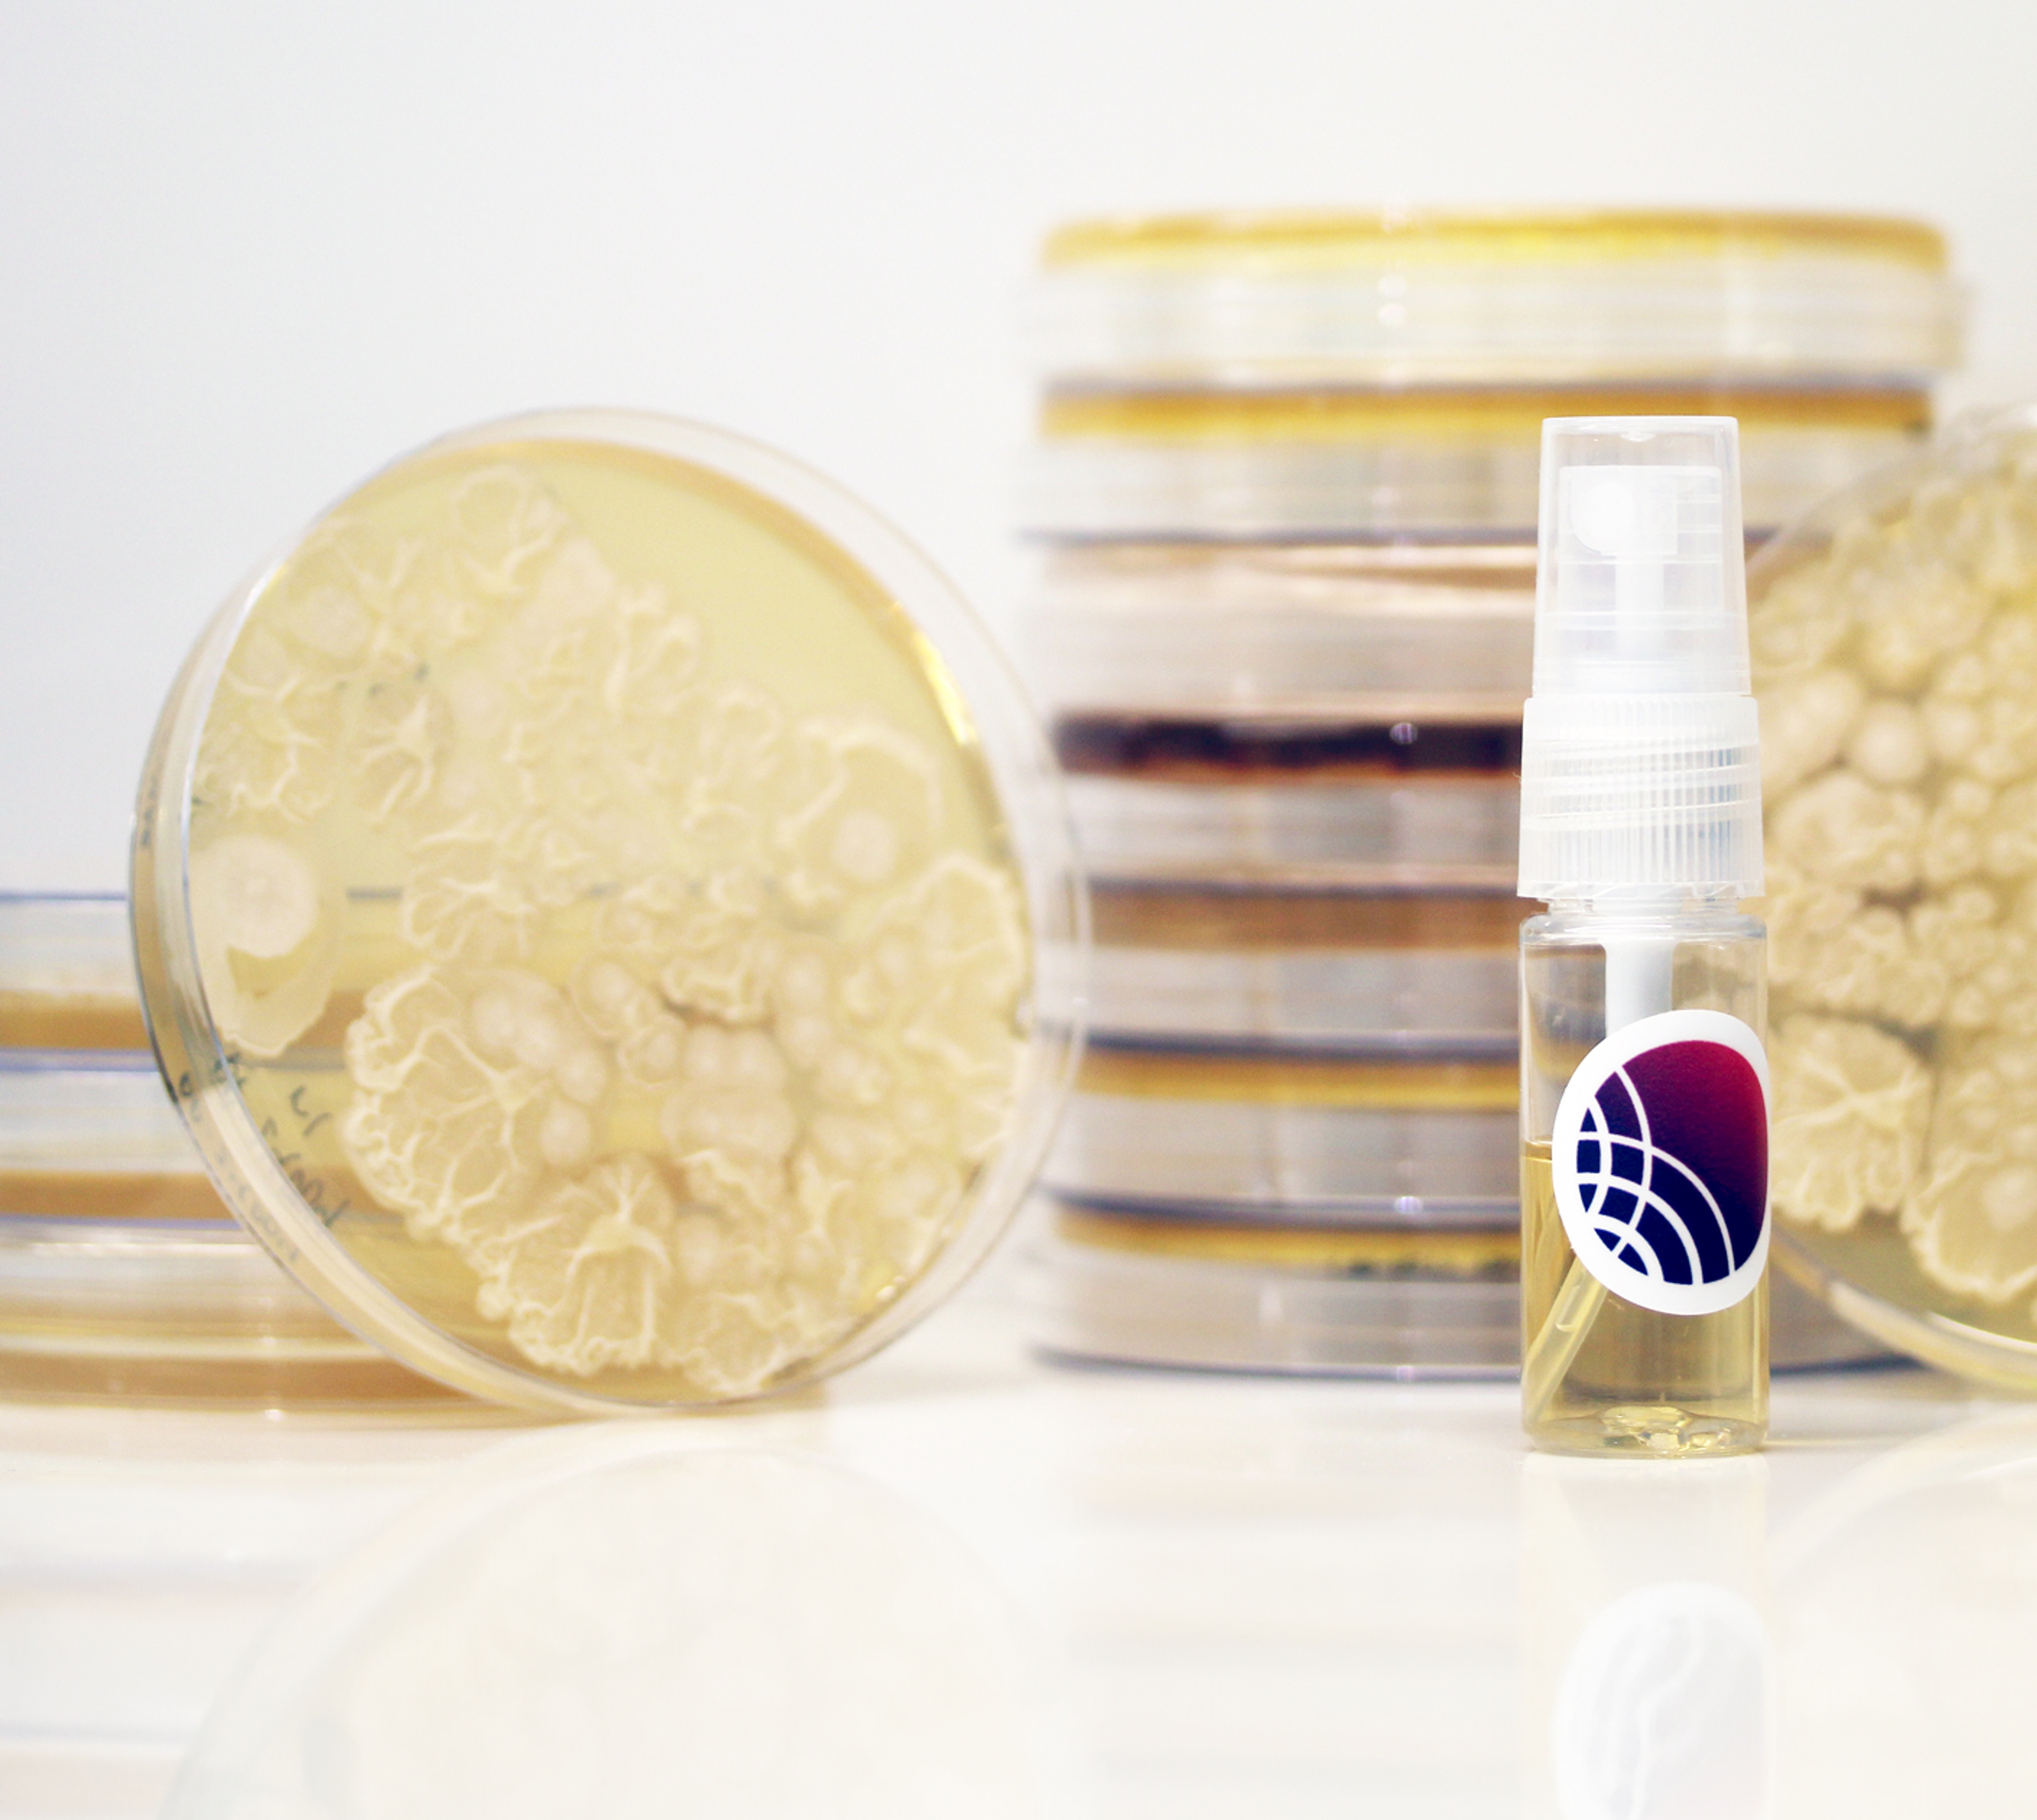

Scaled, structured data
to convert microbial ecology into consumer health products.
The biggest challenge in microbe-based products? Making them work outside the lab. Concerto’s deep ecological insights translate to real-world efficacy for skincare issues, chronic disease, nutrition, and more.
Microbial communities are complex. We make them predictable and engineerable. kChip experimentally generates vast ecological datasets, and our kAI model learns from them—mapping interactions, predicting behavior, and enabling the smartest microbial products.

750 Main Street
Cambridge, MA 02139